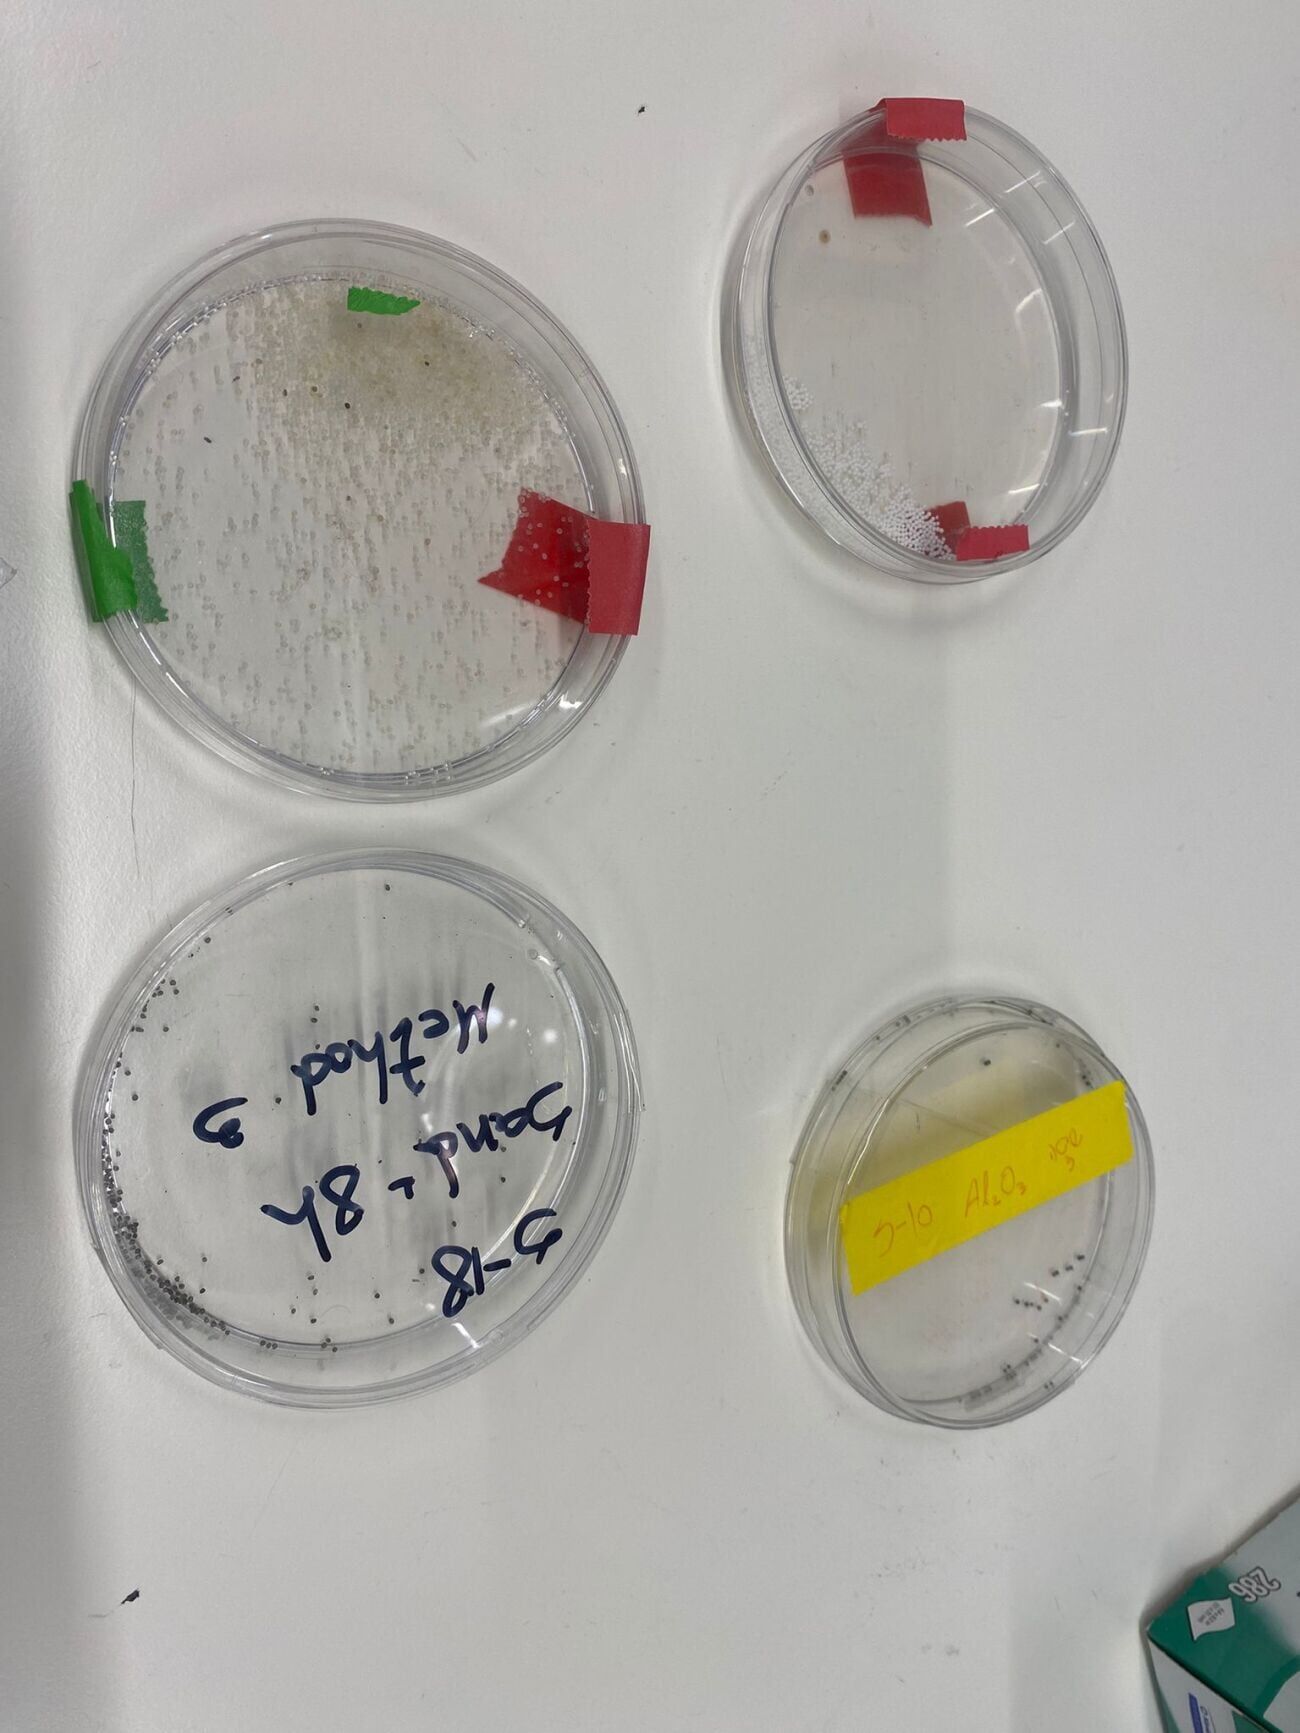

רפואה עתידנית וננוטכנולוגיה: חברי 'ידידים פלוס' בסיור מרתק במעבדות אוניברסיטת תל אביב
בשבוע שעבר התקיים מפגש מעמיק בין קבוצה מצומצמת של משתתפי תוכנית "ידידים פלוס" של אגודת ידידי אוניברסיטת תל אביב לבין חוקרות פורצות דרך במוסד. המפגש נערך בבניין ברודקום למחקר והנדסה בפקולטה להנדסה, ובמסגרתו נסקרה הדרך שבה טכנולוגיות אולטרסאונד וננוטכנולוגיה משפיעות על עולמות הרפואה והסביבה.
במהלך הסיור, המשתתפים ביקרו במעבדתה של פרופ' טלי אילוביץ, שם הוצגו טכנולוגיות חדשניות של אולטרסאונד רפואי מתקדם המיועדות לדימות ולטיפול לא פולשני. בין היתר, למדו המשתתפים כיצד הטכנולוגיה מאפשרת טיפול בגידולים סרטניים ללא מגע ישיר במטופל, וכן העברת תרופות למוח ללא צורך בהתערבות ניתוחית.
בהמשך, נערך ביקור במעבדה לננוטכנולוגיה סביבתית בראשותה של פרופ' אינס צוקר. במעבדה זו נחשפו המבקרים לאופן שבו מפותחים חומרים ותהליכים המיועדים לפתרון בעיות סביבתיות. במהלך ההסבר הוצג כיצד שימוש בחומרים הנבנים בסקאלה ננומטרית מאפשר פתרון יצירתי ויעיל לאתגרים שונים, כגון הסרת מתכות ממים, פירוק של מזהמים אורגניים, והעשרת קרקע בדשן ישירות לשורש הצמח.
הסיור נערך כחלק ממפגשי העשרה לקידום המחקר וההשכלה. למידע נוסף ולהצטרפות למפגשים הבאים של התוכנית, ניתן להיכנס לקישור ההרשמה.

להצטרפות לוואטסאפ חדשות תל אביב-יפו להצטרפות לקבוצת וואטסאפ ששולחת דילים וקופונים לאליאקספרס
באתר זה שולבו סרטונים, תמונות ומידע מהרשתות החברתיות בשימוש לפי סעיף 27א לחוק זכויות יוצרים. במידה וידוע מי צילם שלחו למייל בקשה לצרף קרדיט או להסרה
מנסה לטעון שוב
הצטרפו אלינו!
הצטרפו לקבוצות הוואטסאפ שלנו:
אפליקציה בחנות האפליקציות:
אין עדיין תגובות
אפשר להתחיל את הדיון עם תגובה ראשונה.